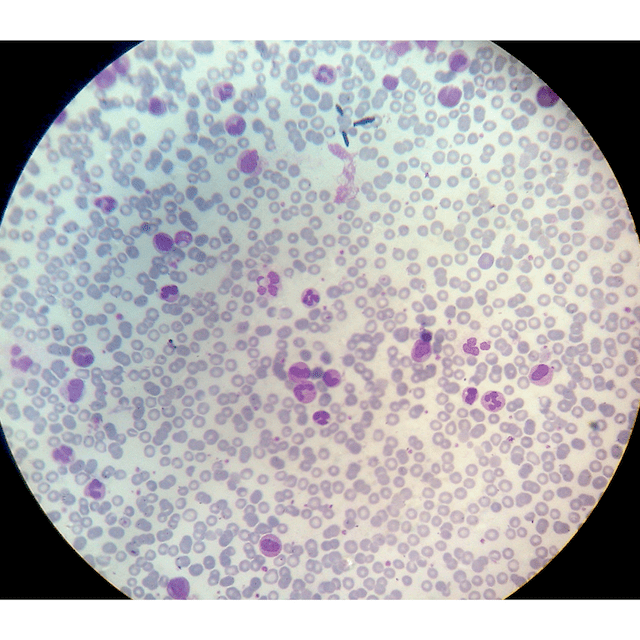

The first question is: “Is the patient producing enough red blood cells?“. This can be answered by checking a reticulocyte count and. If appropriately elevated, the differential shifts toward hemolysis or blood loss. “Hemolysis labs” (LDH, haptoglobin, indirect bilirubin, and plasma free hemoglobin) as well as peripheral smear can help differentiate the two. If the reticulocyte count is low or inappropriately normal (a reticulocyte production index can be calculated to assess appropriateness), then a lack of production is the cause of the anemia. This is usually due to a deficiency in one of the four things that RBCs require for production: EPO, iron, B12, or folate
Iron Study Interpretation

Iron-Deficiency anemia typically manifests as a microcytic anemia
In Anemia of Chronic Disease, the inflammatory molecule hepcidin is produced by the liver. This prevents uptake of iron from the GI tract as well as iron release from the liver. This leads to low total body iron levels as well. With chronic inflammation, the liver uses its energy synthesizing inflammatory agents (such as hepcidin), and therefore does not generate as much transferrin, causing levels to decrease. The transferrin levels decrease proportionately more than the iron levels, causing a decrease in TIBC. Ferritin levels will generally be elevated in anemia of chronic disease, as it is elevated as a non-specific marker of inflammation.
B12/Folate and Homocysteine/Methylmalonic Acid

An inadequacy of either Vitamin B12 or folate may result in a macrocytic, megaloblastic anemia. This condition is further characterized by ineffective erythropoiesis, resulting in intramedullary hemolysis, which leads to elevated indirect bilirubin and LDH levels.
Homocysteine and methylmalonic levels may be checked with folate levels or if Vitamin B12 levels are indeterminate (2.2 – 4.1 ng/mL for folate, 200-400 pg/mL for Vitamin B12).
Because of the reactions shown above, an inadequate supply of folate will lead to a buildup of homocysteine, as the first reaction will not be able to move forward
With an inadequate supply of Vitamin B12, there is also stalling of the first reaction, leading to a buildup of homocysteine, however there will also be a buildup of methylmalonic acid because of the second reaction’s inability to occur. With this, there will also be a decreased amount of Succinyl-CoA available for myelin production and the patient will likely experience neuropathies in addition to anemia.

